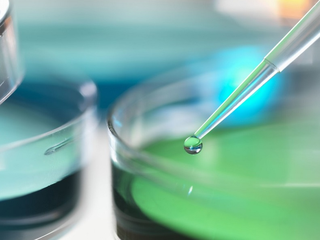

2023年3月13日,来凯医药(Laekna,Inc.)向港交所递交招股书,拟在主板上市。中金公司为独家保荐人。
来凯医药成立于2016年,是一家以科学为驱动、处于临床阶段的生物科技公司。公司有两款核心产品及13种其他管线候选产品。两款核心产品均获诺华授权引进。其中一款核心产品LAE002是一种三磷酸腺苷(ATP)竞争性AKT抑制剂,用于治疗卵巢癌、前列腺癌、乳腺癌及PD-1/PD-L1耐药实体瘤。
另一款核心产品LAE001是雄激素合成抑制剂,可同时抑制细胞色素P450家族17亚族A成员1(CYP17A1)及细胞色素P450家族11亚族B成员2(CYP11B2),用于治疗前列腺癌。
截至最后可行日期,公司们拥有163项专利及专利申请(包括具有全球权利的授权引进专利及专利申请)。
于2021年及2022年,公司研发费用分别为人民币173.3百万元及人民币313.4百万元。于该等期间,归属于核心产品的研发费用分别为人民币130.8百万元及人民币195.0百万元。
公司目前并无任何产品获准用于商业销售,且并未从产品销售中获得任何收入。于往绩纪录期间产生经营亏损。
来凯医药计划将此次IPO募集资金用于迅速推进核心产品之一LAE001的临床开发及批准;用于推进公司另一核心产品LAE002的临床开发及批准;用于加快其他现有管线产品的研发,并不断推进及改进创新的管线产品;用于提高产能及发展制造能力;用于业务发展活动及增强全球网络;用于营运资金及其他一般企业用途。
